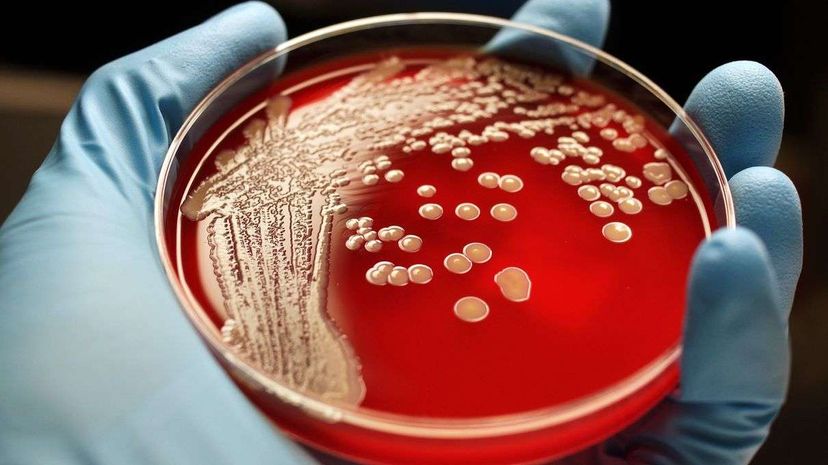
Explore How Bacteria Transform into Drug-Resistant Superbugs

Peter Parker needed a radioactive arachnid bite. Clark Kent got his strength from the sun. Bruce Wayne can just buy himself superpowers. But what does it take for the mighty superbug to develop?
Ten days and a whole bunch of antibiotics.
Unfortunately, this superbug isn't fighting crime and stymieing villains. We're talking antibiotic-resistant bacteria, which has no foe and kills 23,000 people a year in the United States. Now researchers have demonstrated how fast a group of bacteria can adapt to antibiotics placed in their path. (Their findings were published in Science.)
Scientists from Harvard Medical School and the Technion-Israel Institute of Technology in Haifa, Israel, wanted to learn more about how bacteria move and evolve in different environments. So they set up a 2-by-4-foot (60-by-120-centimeter) rectangular petri dish and dosed both ends of it with lots of E. coli and bacterial food for the "bugs" to feast on. On each end, they added increasing amounts of antibiotics, until at the center there were antibiotics at 1,000 times the concentration that E. coli. can normally survive.
Researchers found that when the E. coli arrived at the first incremental dose (enough to kill the bacteria), they predictably stopped moving — but not for long. Soon a bloom appeared where the bacteria mutated to become resistant to the antibiotic, allowing the bacteria to break through the "barrier" to a more concentrated dose that is typically deadly. The bacteria continued like this, creeping through each larger dose as their genes mutated.
After 11 days of being left to their own devices in a sea of stuff designed specifically to kill them, the bacteria conquer the petri dish completely — much like you would expect from a superpowered bug.
Now That's InterestingWhile you might think that only the most resistant bacteria would make it through, researchers found that the most resistant strains aren't always at the forefront and may get trapped behind other less-resistant mutations.